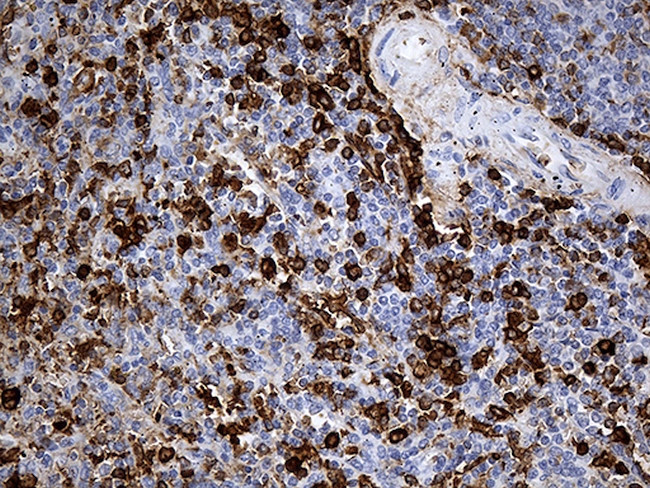
JUP Antibody in Immunohistochemistry (Paraffin) (IHC (P))

Search
OriGene
JUP Monoclonal Antibody (OTI4D5), TrueMAB™
{{$productOrderCtrl.translations['antibody.pdp.commerceCard.promotion.promotions']}}
{{$productOrderCtrl.translations['antibody.pdp.commerceCard.promotion.viewpromo']}}
{{$productOrderCtrl.translations['antibody.pdp.commerceCard.promotion.promocode']}}: {{promo.promoCode}} {{promo.promoTitle}} {{promo.promoDescription}}. {{$productOrderCtrl.translations['antibody.pdp.commerceCard.promotion.learnmore']}}
产品信息
TA812398
种属反应
宿主/亚型
分类
类型
克隆号
抗原
偶联物
形式
浓度
纯化类型
保存液
内含物
保存条件
运输条件
靶标信息
JUP is a major cytoplasmic protein which is the only known constituent common to sub membranous plaques of both desmosomes and intermediate junctions. This protein forms distinct complexes with cadherins and desmosomal cadherins and is a member of the catenin family since it contains a distinct repeating amino acid motif called the armadillo repeat.
仅用于科研。不用于诊断过程。未经明确授权不得转售。
篇参考文献 (0)
生物信息学
蛋白别名: catenin (cadherin-associated protein), gamma 80kDa; Catenin gamma; Desmoplakin III; Desmoplakin-3; Junction plakoglobin; OTTHUMP00000164735
基因别名: ARVD12; CTNNG; DP3; DPIII; JUP; PDGB; PKGB
UniProt ID: (Human) P14923
Entrez Gene ID: (Human) 3728